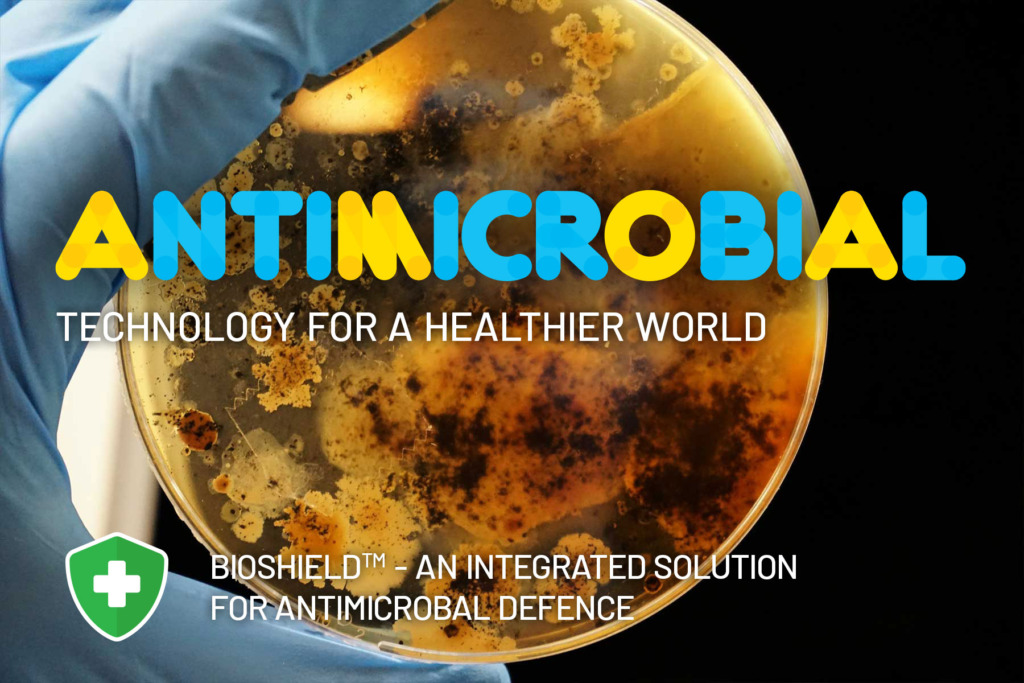

Antimicrobial Tech for a Healthier World
November 25, 2020
Packaging touches every area of our lives. With the effects of coronavirus potentially with us for years to come, the packaging world has never been more under the microscope. Ensuring the highest hygiene levels of frequently handled packaging such as containers and caps is critical. Especially, when you consider that 80% of infectious diseases start from surface contact.
The good news is that packaging has massive potential to be a saviour rather than a transmission danger. This is where antimicrobial technology really comes into its own. In various forms, it has been shaping the packaging design of our increasingly health-conscious world for some time now. As they say, ‘The truth is in the detail’. So, let’s take a closer look at antimicrobial tech’s power to help shield us from biological and bacterial harm.
Shielding customers from the invisible enemy
Though we can’t see them, bacteria and fungi are all around us. Unchecked, they can quickly reproduce and cause unpleasant odours, contamination and rapidly spread viruses and diseases. Thankfully, we have antimicrobials as our ‘biological shield’. Think of them as the superbug’s ‘Kryptonite’.
In technical terms, an antimicrobial is an agent that kills microorganisms or stops their growth. Antimicrobial materials including medicines can be grouped according to the microorganisms they act primarily against. For example, antibiotics are used against bacteria and antifungals are used against fungi. Antimicrobial technologies are effective against a broad spectrum of harmful microorganisms and minimise the presence of viruses, bacteria, mould, and fungi.
More than a silver lining
The protective properties of metal ions have been known since ancient times. This has led to the use of silver, copper or other elements as highly effective antibacterials in catheters, treating burns, and dental work. Antimicrobials using this metal ion technology destroy the organisms’ cells from the inside out. This prevents them from mutating into antibiotic-resistant superbugs. The huge advantage from a shielding point of view is that their effectiveness doesn’t diminish over time.
Creating high-tech hygienic packaging

Photo by Jonathan Chng on Unsplash
In tandem with nations scrambling to find a COVID-19 vaccine, technologists are escalating the incorporation of antimicrobial materials across the packaging world. Cutting-edge developments consist of an antimicrobial coating on plastic that kills bacteria by making the surface inhospitable. This can also be achieved by the inclusion of ‘metal ion’ additives when manufacturing.
Caps and Closures is working with leading antimicrobial material providers to deliver technology that can be added to the packaging at any stage of the process. Quite fittingly, we’ve named this advanced protection BioShield™. It’s compatible with materials such as plastics, paints, and textiles.
Adding BioShield™ to your packaging will:
- Reduce bacteria by 99.99%
- Deactivate some viruses
- Reduce cross-contamination
- Make it easier to keep hygienic and clean
- Offer lasting protection from bacteria and mould
Now’s the time for us to protect brand reputation, product quality and, most of all, add to the health and peace of mind of our customers and community.
Take a deeper look into all the possibilities of BioShield™ antimicrobial packaging. Book a complimentary consultation with our Director of Innovation.
There’s massive potential awaiting under the microscope!


